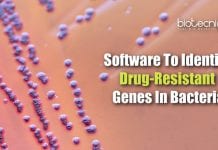
WSU Researchers Develop Software To Identify Drug-Resistant Genes In Bacteria Software To Find Drug-Resistance In Bacteria

Biotecnika Times – Newsletter 09.07.2020 – CSIR-IGIB COVID-19 Project Online Interview, THSTI
Biotecnika Times - CSIR-IGIB COVID-19 Project Online Interview, THSTI
CSIR-IGIB COVID-19 Testing Project Recruitment – Online Interview
CSIR-IGIB Recruitment – Online Interview For MSc/BTech/PhD. MSc/BTech/PhD Life...
Novozymes Life Sciences Research Associate – MSc & MTech Apply Online
Novozymes Life Sciences Associate - MSc & MTech Apply Online
Novozymes Life Sciences Associate - MSc & MTech Apply Online. Candidates with an msc /...
PGIMER Food Technology Dietary Lab Supervisor Recruitment
PGIMER Food Technology Dietary Lab Supervisor Recruitment
PGIMER Food Technology Dietary Lab Supervisor Recruitment. MSc Food Technology Candidates Apply. Research jobs at PGIMER. PGIMER is...
PGIMER Human Genetics & Biotechnology Research Fellow Job
PGIMER Human Genetics & Biotechnology Research Fellow Job
PGIMER Human Genetics & Biotechnology Research Fellow Job. MSc Biotech / Human Genetics & Biochemistry Candidates Apply....
NIT Rourkela Dept of Life Science Junior Research Fellow Recruitment
NIT Rourkela Latest Job - Junior Research Fellow Vacancy
NIT Rourkela Latest Job - Junior Research Fellow Vacancy. MSc Life Science/ Microbiology/ Biochemistry/ Biotechnology/Botany/ Zoology/...
InnoDx – BSC BioNEST Bio-Incubator Freshers Life Sciences Job
InnoDx - BSC BioNEST Bio-Incubator Freshers Life Sciences Job
InnoDx - BSC BioNEST Bio-Incubator Freshers Life Sciences Job. RCB is hiring MSc Biology, Biotechnology, Immunology...
NABI Dept of Biotech Recruitment 2020 – Applications Invited
NABI Dept of Biotech Recruitment 2020 - Applications Invited
NABI Dept of Biotech Recruitment 2020 - Applications Invited. Govt NABI Research Fellow Jobs. National Agri-Food...
CSIR-IGIB COVID-19 Testing Project Recruitment – Online Interview
CSIR-IGIB Recruitment - Online Interview For MSc/BTech/PhD
CSIR-IGIB Recruitment - Online Interview For MSc/BTech/PhD. MSc/BTech/PhD Life Sciences/Computational Biology/Bioinformatics/ Biochemistry/ Biotechnology/ Microbiology candidates are eligible to...
WSU Researchers Develop Software To Identify Drug-Resistant Genes In Bacteria
Software To Find Drug-Resistance In Bacteria By WSU Researchers
An easy-to-use software program to identify drug-resistant genes in bacteria has been developed by researchers at...
Human ‘Cell Membrane On Chip’ To Accelerate COVID-19 Drug Discovery
Scientists have developed a human cell 'membrane on a chip' to continuously monitor how infectious agents and drugs interact with our cells, in an...
COVID-19 Testing Lab in Aizawl Developed By DBT Supported Program
DBT supported program helps establish COVID-19 testing laboratory in Aizawl
The Mizoram government has established a COVID-19 testing laboratory at Zoram
Medical College in Aizawl. This...
TMC-Dr B. Borooah Cancer Institute Life Science & Biotech Job With Rs. 78,000 pm...
Dr BBCI Life Science & Biotech Job With Rs. 78,000 pm Pay
Dr BBCI Life Science & Biotech Job With Rs. 78,000 pm Pay. PhD...
THSTI Life Sciences / Virology Jobs With Up to Rs. 1 Lakh pm Pay
THSTI Virology Jobs - Research Associate/Assistant Vacancies
THSTI Virology Jobs - Research Associate/Assistant Vacancies. BSc/MSc/PhD Life Sciences/ Biotech/ Biochem/ Microbiology/ Immunology and Virology candidates check...
Biotecnika Times – Newsletter 08.07.2020 – ACTREC Cancer R&D Job, NCBS-TIFR Rs. 67,700 pm
Biotecnika Times - ACTREC Cancer R&D Job, NCBS-TIFR Rs. 67,700 pm
NCBS-TIFR Job With Rs. 67,700 pm Pay – Biotech & Life Sciences Apply
NCBS Job...
Rare Case Of Brain-Eating Amoeba Infection Reported In Florida
Rare Case Of Brain-eating Amoeba Reported in Florida
According to health officials in the US state, a case of a rare brain-eating amoeba has been...